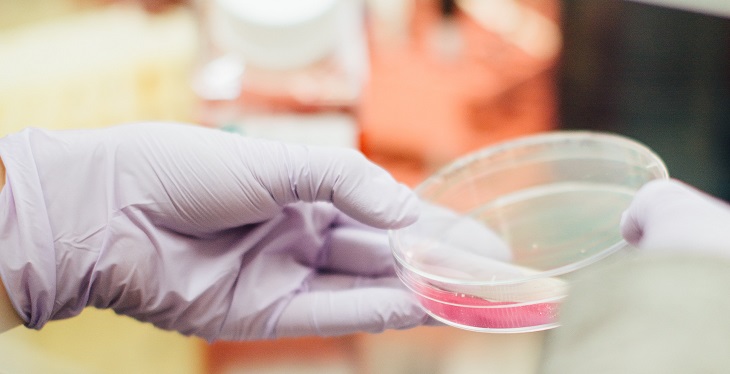

לבני זוג שהיו נשואים לא היו ילדים והם גם לא קיימו יחסי מין. לאחר חמש שנות נישואין התגלה כי האישה בהריון בחודש השלישי, והבעל מיהר להגיש תביעת גירושין, בטענה שאינו האב.
חודש וחצי לפני הלידה, הצדדים הגיעו להסכם גירושין שקיבל תוקף של פסק דין ובו נכתב: "האישה מצהירה כי היא בהריון וכשייוולד הילוד היא תישא במזונותיו ופרנסתו של הילוד ומצהירה שיש בידיה את היכולת בכך, ובמידה והיא תפר הצהרה זו, ותתבע אותו בכל ערכאה שהיא ויחויב הבעל א', במזונות הילוד, הרי היא תשפה ותשלם להנ"ל במקביל כל סכום שיחויב, עבור מזונות הקטין".
הבן נרשם במרשם האוכלוסין כבנו של האיש, ושבועיים לאחר הלידה הצדדים התגרשו באופן רשמי. כשהגיע הבן לגיל שמונה, האב הרשום הגיש תביעה לבית הדין, שם טען כי הבן אינו בנו ויש להורות לרשות האוכלוסין למחוק את רישומו כאביו. בית הדין הפנה את הצדדים להרכב המיוחד לענייני יוחסין.
בדיון שהתקיים בפני הרכב היוחסין טענה האישה כי בעלה סבל מאין אונות ולאורך כל תקופת הנישואין הם קיימו יחסים פעמיים בלבד, כשלצורך זאת נטל גלולות שאפשרו את קיום היחסים. עובדה זאת התגלתה לה מיד אחרי החתונה, ואף על פי כן היא נותרה להתגורר אתו וסברה שתוכל להרות מהפריה.
הבעל לשעבר אמר אף הוא כי הצליחו לקיים יחסים פעמיים בלבד, אולם הוסיף ואמר כי פעמים רבות ניסה לקיים אתה יחסים אך לא הצליח "להתקשות". לדבריו, "היה יוצא לי מים", רוצה לומר – היתה "פליטה של נוזל כלשהו בלי מעשה ביאה, דבר שקרה פעמים רבות".
תיקו הרפואי של הבעל לשעבר הוזמן על ידי בית הדין, והתברר כי אין בו כל חומר היכול לשפוך אור על פוריותו. בשל כך, בית הדין החליט לדון במספר סוגיות, אחת מהן היא האם יכולה אישה להתעבר באופן זה בלא מעשה ביאה.
"הבעל אמר כי ניסה לבוא על אשתו כדרך כל הארץ, אולם לא עלה הדבר בידו מפני שלא הצליח להתקשות, אך יצא ממנו חומר נוזלי. הבעל מעט מוגבל וקיים קושי לברר באופן מדויק האם הוא יורה כחץ, אך דומה שכך היא המציאות", הציג הרב אליהו אריאל אדרי את הסיטואציה.
לאחר שבדק את ההלכות בסוגייה תוך התייחסות לחשש ממזרות, הגיע למסקנה: "לענ"ד מכלל ספק לא נפקא, שאפשר שתתעבר גם בזה"ז אף שלא ירה כחץ בתוך רחמה של האישה ממש… עדיין לא הייתי עושה מעשה להתיר בדיקת זרע מטעם זה בלבד. אולם, הבעל לשעבר לא קיים מצות פו"ר, וגם מטעם זה יש להתיר את הבדיקה".
הרב אדרי המשיך והסביר: "בדיונים אמר כי הופנה בעבר לבדיקת זרע, אולם עיון בתיקו הרפואי העלה כי אין כל אבחנה רפואית שיכולה ללמד על בעיית פוריות הקיימת אצלו, ולמעשה לא עבר כל טיפול רפואי הנוגע לפוריותו. לענ"ד, כיוון שלא קיים מצות פו"ר ויתכן שעל ידי בדיקת הזרע יוכל למצוא מזור ותרופה, חובה עליו לבצע בדיקה זו כדי לפרות ולרבות. הבעל, כאמור בתסקיר שירותי הרווחה שהוגש לבית הדין, הינו מוגבל במקצת, ואין להתפלא שמעולם לא פנה לכל טיפול שהוא".
בסופו של דבר פסק בית הדין כי הבעל לשעבר מופנה לאלתר לבדיקת זרע, תוך הנחיות ספציפיות כדי לא לעבור על איסור השחתת זרע לבטלה: "בדיקת הזרע תיעשה שלא על ידי מעשה בידיים, אלא באופן של גרמא. ככל שלא יהא מנוס מלעשות מעשה בידיים, נא ימציא הבעל לשעבר חוות דעת רפואית המבהירה מדוע יש צורך לעשות כן. מטרת הבדיקה לבדוק האם הבעל לשעבר פורה כיום, ככל שבאפשרותו להזריע יש לבדוק האם ההזרעה היא בדרך של טפטוף או בדרך של זרימה".
* הכותבת, עו"ד דפנה לביא, היא עורכת דין לענייני משפחה ומרכזת מדור המשפחה באתר "פוסטה"








